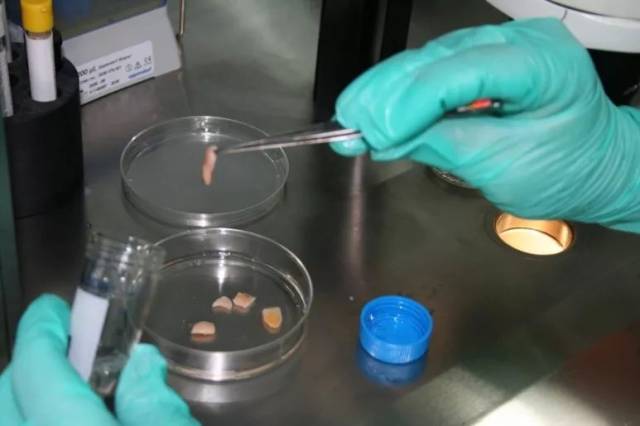
女性生育力保存之
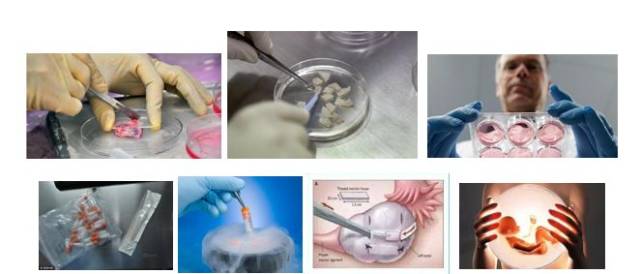
女性生育力保存之

医生

老李
医生,那对于患有恶性肿瘤,但还年轻的妹儿咋个办呢?以后还有机会当妈妈吗?
莫急莫急,对于女性生育力的保存除了冷冻卵子和胚胎,还可以冷冻卵巢组织。

医生

老李
真的呀医生,太好了!那妹儿有希望了,你快给我说下这卵巢组织冷冻是咋个回事嘛。
别急别急,本期作者就来给大家谈谈卵巢组织冷冻的前世今生。

医生
今日主题:
女性生育力保存之——卵巢组织冷冻

Duang
本期作者就来给大家谈谈卵巢组织冷冻的前世今生
01
卵巢组织及其功能
首先,我们来了解一下什么是卵巢组织。
卵巢是女性的生殖内分泌器官,主要功能是产生卵子和分泌类固醇激素。人有一对卵巢,位于小骨盆的后部,外侧由骨盆漏斗韧带连于盆壁,内侧由子宫卵巢韧带连于子宫。
成年女性卵巢大小约4 cm×3cm×1cm,重量约5g左右,青春期前、成年后及绝经期后卵巢大小、形状及重量有差异。

小小的卵巢有什么功能呢?是不是就是产生卵子生育孩子呀?
妹儿些可别小看卵巢呀!
它的功能除了提供卵子完成生殖功能还与女性特有的内分泌功能产生性激素、女性的基础代谢、心血管功能及骨质变化等密切相关。
02
女性生育力保存的方法
医生你跟我们说一下女性生育力保存的方法有哪些嘛?

目前女性生殖功能的保存建立在各种生殖细胞和组织的深低温保存基础之上,主要包括以下几种技术:
(1)胚胎冷冻:
说简单点就是卵子和精子受精之后,形成胚胎,再冻起来!到时候直接解冻移植就好了嘛。
随着辅助生育技术的发展,胚胎冷冻技术已较为成熟,但胚胎冷冻受到年龄、婚姻状况、伦理法律等条件的制约,因此仅适合部分已婚的患者。

(2)成熟卵母细胞冷冻:
意思就是控制性超促排卵后取卵,不跟精子受精,把那些成熟卵子直接冻起来!为啥子不受精嘞,这个肯定是针对那些暂时还没有找到合适精子的未婚妹儿嘛!
成熟卵母细胞深低温保存为年轻未婚女性的配子保存提供了可能性。但它仍需要进行控制性超促排卵和手术取卵,由于患者开始恶性肿瘤放化疗的急迫性以及激素敏感性肿瘤患者不适合进行控制性超促排卵,使该技术临床开展困难。
(3)不成熟卵母细胞冷冻:
这个呢,就不用超促排卵,而是直接取卵,取出来的可能大部分都是不成熟卵,也不跟精子受精,直接冻起来。
该技术避免了使用超促排卵,但由于取卵操作困难,以及体外成熟技术的限制和不成熟卵子冷冻的安全性问题,使其目前成功率很低。

(4)卵巢组织冷冻:
顾名思义就是直接取一坨卵巢组织出来,然后冻起来!
卵巢组织深低温保存具有明显优势:
①不需要使用超促排卵治疗,可以在月经周期的任何时间进行,不延误恶性肿瘤患者的治疗时机;
②不受年龄和婚姻状况的限制,不需要男方精子参与,是青春期前女性保存生育力的唯一方法;
③卵巢皮质含有大量的始基卵泡,其体积较小,冷冻保护剂能迅速穿透其内部卵细胞;和生长卵泡相比,其代谢不活跃,透明带缺乏,因此冷冻对其造成的损伤也较小;
④卵巢组织冻融移植后由于卵巢周期的恢复,同时可使患者的内分泌功能得到恢复。因而对女性生育力和生殖内分泌功能保存具有极大优势。
03
卵巢组织冷冻
听起来卵巢组织冷冻那么好,到底是咋个冻呢?是不是像家里冻肉一样放在-20度冰箱就可以了呀?

妹儿,怎么可能这么简单呢,来让我告诉你目前主要使用的方法有慢速冷冻法和玻璃化快速冷冻法。
①慢速冷冻法也称程序冷冻法:
在慢速冷冻中,随着细胞外温度的逐渐降低和细胞外冰晶的形成,细胞以一种平衡的方式逐步脱水,因此也被称为平衡冷冻法。
②玻璃化冷冻法:
由于冷冻液体积很小,故降温十分迅速,在15000~30000℃/min的快速冷冻速率中,液体的黏度增加,当黏度达到临界值时即发生凝固化,形成玻璃样固体。
玻璃化冷冻法能有效地降低细胞溶质性损伤;有效地抑制了细胞内冰晶对细胞、组织的损伤。
哎呀,医生你讲的那么复杂!

好嘛,我简单的流程图来给你简单描述一下:
卵巢组织提取→ 皮质层切片→ 脱水→ 加入冷冻保存剂→-196℃液氮保存 →“唤醒”卵巢组织→ 自体移植
另外给大家透露一下!
卵巢组织冷冻技术中,我科汪燕教授和肖准教授发明的多种新型技术,均已获得了国家发明专利,其中包括新型玻璃化冷冻法,即NIV法。
再来看一下我们科室为了保证冷冻效果发明的专利传说中的NIV法。
据说,,,
该方法是起源于成都的串串!
人家冷冻卵巢组织都是整一坨丢进去冷冻,而我们的NIV法则是把卵巢组织切成片片,串起来冷冻,增加了冷冻表面积,可以让卵巢组织更好的保存起来,这样是不是更入味?

哈哈哈,咱们华西的教授是不是很有才呀!(???医生你确定这不是冷锅串串哇,哈哈哈)

医生,那卵巢组织冷冻的效果如何呢?



